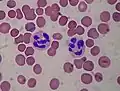

Proteínas de fase aguda
As proteínas de fase aguda são uma classe de proteínas cuja concentração plasmática aumenta (proteínas de fase aguda positivas) ou diminui (proteínas de fase aguda negativas) em resposta à inflamação. Essa resposta é chamada de resposta de fase aguda.
Em resposta à danos, células inflamatórias locais (neutrófilos, granulócitos e macrófagos) secretam diversas citocinas na corrente sanguínea, notavelmente as interleucinas IL1, IL6 e IL8, além de TNFα. O fígado responde produzindo um número de reagentes de fase aguda. Ao mesmo tempo, a produção de diversas outras proteínas é reduzida; denominadas, então, reagentes negativos da fase aguda. O aumento de certas proteínas de fase aguda pelo fígado pode contribuir para a promoção da sepse.[1]
Positivas
Proteínas de fase aguda positivas servem a diversas funções fisiológicas do sistema imune. Algumas agem destruindo ou inibindo o crescimento de micóbios, ex: e.g., proteína C-reactiva , proteína ligadora de manose (MBP),[2] fatores do complemento, ferritina, ceruloplasmina, amilóide A sérico e haptoglobina. Outros retroalimentam negativamente a resposta inflamatória, ex: sepinas. A macroglobulina alfa-2 e fatores de coagulação também podem ser aumentados, com efeito pró-coagulante, criando coágulos que limitam a entrada de patógenos. Além disso, alguns produtos do sistema de coagulação interagem com o sistema imune inato através de sua habilidade de aumentar a permeabilidade vascular além de agir como quimiocinas para fagócitos.
| Proteína | Função no Sistema imune |
|---|---|
| Proteína C-reativa | Opsonina em micróbios[3] (não é uma proteína de fase aguda em ratos), ativa via clássica do complemento, modulando ação do anticorpo - simula ação da C1 para posterior clivagem de C4 |
| Componente sérico amilóide P | Opsonina |
| Amilóide sérico A |
|
| Fatores do complemento | Opsonização, lise e aglutinação de células alvo. Quimiotaxia |
| Lectina ligadora de manose | Ativação da via da lectina de ativação do complemento |
| Fibrinogênio, protrombina, fator VIII, fator de von Willebrand |
Fatores de coagulação, capturam micróbios invasores em coágulos. Alguns podem auxiliar na quimiotaxia |
| Plasminogênio | Degradação de coágulos |
| Macroglobulina alfa 2 |
|
| Ferritina | Liga-se a ferro, inibindo a captura de ferro por microorganismos [5] |
| Hepcidina[6] | Estimula a internalização de ferroportina, prevenindo a liberação de ferro ligado à ferritina em enterócitos e macrófagos intestinais |
| Ceruloplasmina | Oxida o ferro, facilitando a ação de ferritina e inibindo a captura de ferro por microorganismos |
| Haptoglobina | Liga-se a hemoglobina, inibindo a captura de ferros por micróbios |
| Orosomucóide (glicoproteínia ácida alfa-1, AGP) | Carreador de esteróides |
| Antitripsina alfa 1 | Serpina, regula inflamação negativamente |
| Antiquimotripstina alfa 1 | Serpina, regula negativamente inflamação |
Negativas
Proteínas de fase aguda negativas tem sua concentração diminuída pela inflamação. Exemplos incluem albumina,[7] transferrina,[7] transtiretina,[7] proteína ligadora de retinol, antitrombina e transcortina. A diminuição de tais proteínas pode ser usada como marcadores de inflamação . O papel fisiológico da diminuição da síntese de tais proteínas é geralmente a economia de aminoácidos para a produção mais efetiva de proteínas de fase aguda; Teoricamente, uma diminuição em transferrina poderia também ser desencadeada por uma regulação positiva dos receptores de transferrina, mas esses aparentemente não mudam com a inflamação.[8]
Significância Clínica
A medição de diversas proteínas de fase aguda, especialmente a proteína C reativa, é um marcador útil para inflamação na patologia clínica médica e veterinária. Ela se correlaciona com a taxa de sedimentação de eritrócitos (ESR), apesar de que nem sempre diretamente. Isso se deve ao ESR ser altamente dependente do aumento de fibrinogênio, um reagente de fase aguda com uma meia vida de aproximadamente 1 semana. Essa proteção irá, então, permanecer em níveis elevados por bastante tempo após o estímulo inflamatório se encerrar. Em contras, a proteína C reativa (com meia vida de 6 a 8 horas) aumenta rapidamente e pode em pouco tempo voltar aos níveis normais se algum tratamento é empregado. Por exemplo, em lupus eritromatoso sistêmico ativo, é possível encontrar um ESR elevado mas uma taxa de proteína reativa C normal.
Elas podem indicar também falência hepática.[9]
Ver também
- Wikipedia:MeSH_D12.776#MeSH_D12.776.124.050_---_acute-phase_proteins
Referências
- ↑ Abbas, A., Lichtman, A., & Pillai, S. (2012).
- ↑ B L Herpers, H Endeman, B A W de Jong, B M de Jongh, J C Grutters, D H Biesma, and H van Velzen-Blad.
- ↑ Lippincott's Illustrated Reviews: Immunology.
- ↑ Boer JP, Creasey AA, Chang A, Abbink JJ, et al. (1993). «Alpha-2-macroglobulin functions as an inhibitor of fibrinolytic, clotting, and neutrophilic proteinases in sepsis: studies using a baboon model». Infect Immun. 61 (12): 5035–5043
- ↑ http://cdn.intechopen.com/pdfs/21451/InTech-Acute_phase_proteins_ferritin_and_ferritin_isoforms.pdf
- ↑ Vecchi C, Montosi G, Zhang K; et al. (agosto de 2009). «ER stress controls iron metabolism through induction of hepcidin». Science. 325 (5942): 877–80. PMC 2923557
. PMID 19679815. doi:10.1126/science.1176639
- ↑ a b c Ritchie RF, Palomaki GE, Neveux LM, Navolotskaia O, Ledue TB, Craig WY (1999). «Reference distributions for the negative acute-phase serum proteins, albumin, transferrin, and transthyretin: a practical, simple and clinically relevant approach in a large cohort». J. Clin. Lab. Anal. 13 (6): 273–9. PMID 10633294. doi:10.1002/(SICI)1098-2825(1999)13:6<273::AID-JCLA4>3.0.CO;2-X
- ↑ Chua E, Clague JE, Sharma AK, Horan MA, Lombard M (outubro de 1999). «Serum transferrin receptor assay in iron deficiency anaemia and anaemia of chronic disease in the elderly». QJM. 92 (10): 587–94. PMID 10627880. doi:10.1093/qjmed/92.10.587
- ↑ Ananian P, Hardwigsen J, Bernard D, Le Treut YP (2005). «Serum acute-phase protein level as indicator for liver failure after liver resection». Hepatogastroenterology. 52 (63): 857–61. PMID 15966220
Ligações externas
- MeSH Acute-Phase+Proteins